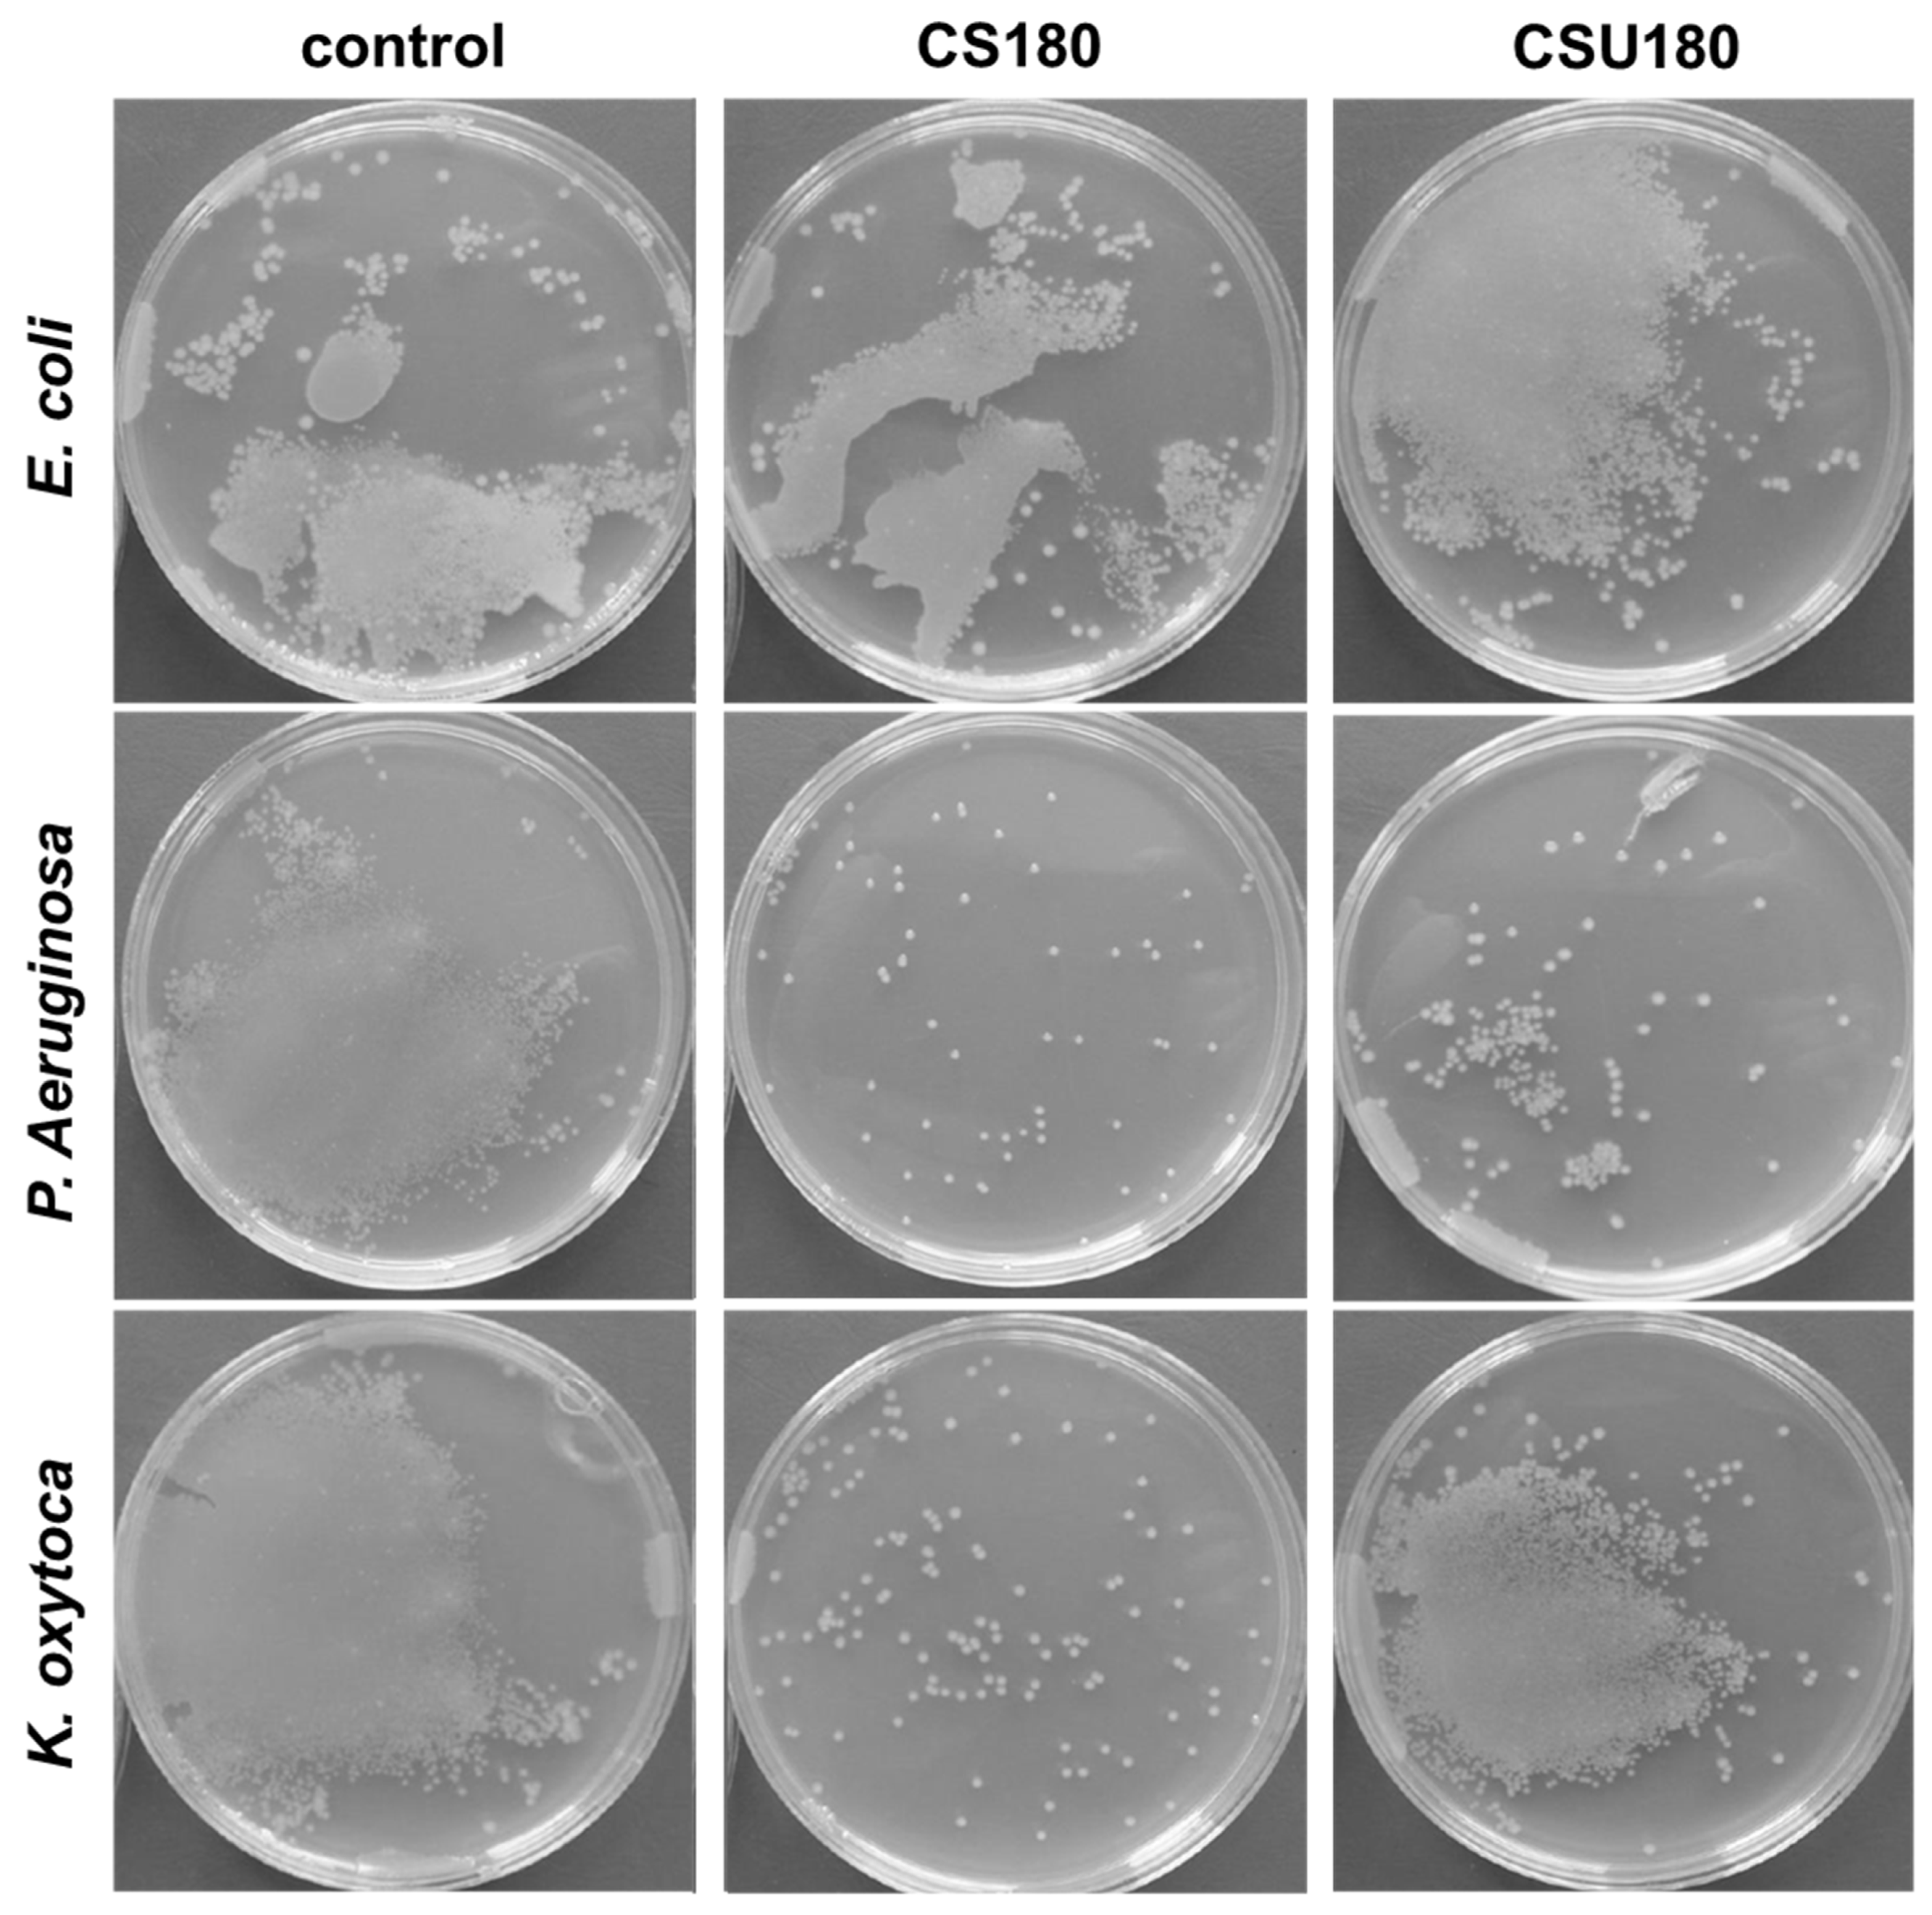
Processes 09 00061 g008

Biomass-Derived Nitrogen Functionalized Carbon Nanodots and Their Anti-Biofouling Properties
Abstract
1. Introduction
2. Materials and Methods
2.1. Chemicals
2.2. Synthesis of Carbon Dots
2.3. Incorporation of CNDs into Membranes
2.4. Antimicrobial Activity Tests
2.5. Characterization
3. Results and Discussion
3.1. Surface Functional Groups and Formation of CNDs
3.2. Structural Features of CNDs
3.3. UV-Vis Absorption and Fluorescence Properties of CNDs
3.4. Incorporation of CNDs into Membranes and Their Antimicrobial Properties
4. Conclusions
Supplementary Materials
Author Contributions
Funding
Acknowledgments
Conflicts of Interest
References
- Liu, H.; Ye, T.; Mao, C. Fluorescent carbon nanoparticles derived from candle soot. Angew. Chem. Int. Ed. 2007, 46, 6473–6475. [Google Scholar] [CrossRef] [PubMed]
- Peng, H.; Travas-Sejdic, J. Simple aqueous solution route to luminescent carbogenic dots from carbohydrates. Chem. Mater. 2009, 21, 5563–5565. [Google Scholar] [CrossRef]
- Li, H.; He, X.; Liu, Y.; Huang, H.; Lian, S.; Lee, S.T.; Kang, Z. One-step ultrasonic synthesis of water-soluble carbon nanoparticles with excellent photoluminescent properties. Carbon N. Y. 2011, 49, 605–609. [Google Scholar] [CrossRef]
- Xu, M.; Huang, Q.; Sun, R.; Wang, X. Simultaneously obtaining fluorescent carbon dots and porous active carbon for supercapacitors from biomass. RSC Adv. 2016, 6, 88674–88682. [Google Scholar] [CrossRef]
- Zhao, S.; Lan, M.; Zhu, X.; Xue, H.; Ng, T.W.; Meng, X.; Lee, C.S.; Wang, P.; Zhang, W. Green Synthesis of Bifunctional Fluorescent Carbon Dots from Garlic for Cellular Imaging and Free Radical Scavenging. ACS Appl. Mater. Interfaces 2015, 7, 17054–17060. [Google Scholar] [CrossRef]
- Qiao, Z.A.; Wang, Y.; Gao, Y.; Li, H.; Dai, T.; Liu, Y.; Huo, Q. Commercially activated carbon as the source for producing multicolor photoluminescent carbon dots by chemical oxidation. Chem. Commun. 2010, 46, 8812–8814. [Google Scholar] [CrossRef]
- Rybarczyk, M.K.; Lieder, M.; Jablonska, M. N-doped mesoporous carbon nanosheets obtained by pyrolysis of a chitosan-melamine mixture for the oxygen reduction reaction in alkaline media. RSC Adv. 2015, 5, 44969–44977. [Google Scholar] [CrossRef]
- Zhao, Q.L.; Zhang, Z.L.; Huang, B.H.; Peng, J.; Zhang, M.; Pang, D.W. Facile preparation of low cytotoxicity fluorescent carbon nanocrystals by electrooxidation of graphite. Chem. Commun. 2008, 41, 5116–5118. [Google Scholar] [CrossRef]
- Tadyszak, K.; Musiał, A.; Ostrowski, A.; Wychowaniec, J.K. Unraveling origins of EPR spectrum in graphene oxide quantum dots. Nanomaterials 2020, 10, 798. [Google Scholar] [CrossRef]
- Cringoli, M.C.; Kralj, S.; Kurbasic, M.; Urban, M.; Marchesan, S. Luminescent supramolecular hydrogels from a tripeptide and nitrogen-doped carbon nanodots. Beilstein J. Nanotechnol. 2017, 8, 1553–1562. [Google Scholar] [CrossRef]
- Briscoe, J.; Marinovic, A.; Sevilla, M.; Dunn, S.; Titirici, M. Biomass-Derived Carbon Quantum Dot Sensitizers for Solid-State Nanostructured Solar Cells. Angew. Chem. Int. Ed. 2015, 54, 4463–4468. [Google Scholar] [CrossRef] [PubMed]
- Barra, A.; Alves, Z.; Ferreira, N.M.; Martins, M.A.; Oliveira, H.; Ferreira, L.P.; Cruz, M.M.; Carvalho, M.D.D.; Neumayer, S.M.; Rodriguez, B.J.; et al. Biocompatible chitosan-based composites with properties suitable for hyperthermia therapy. J. Mater. Chem. B 2020, 8, 1256–1265. [Google Scholar] [CrossRef] [PubMed]
- Khan, A.; Goepel, M.; Colmenares, J.C.; Gläser, R. Chitosan-Based N-Doped Carbon Materials for Electrocatalytic and Photocatalytic Applications. ACS Sustain. Chem. Eng. 2020, 8, 4708–4727. [Google Scholar] [CrossRef]
- Yang, Y.; Cui, J.; Zheng, M.; Hu, C.; Tan, S.; Xiao, Y.; Yang, Q.; Liu, Y. One-step synthesis of amino-functionalized fluorescent carbon nanoparticles by hydrothermal carbonization of chitosan. Chem. Commun. 2012, 48, 380–382. [Google Scholar] [CrossRef] [PubMed]
- Wang, L.; Li, B.; Xu, F.; Shi, X.; Feng, D.; Wei, D.; Li, Y.; Feng, Y.; Wang, Y.; Jia, D.; et al. High-yield synthesis of strong photoluminescent N-doped carbon nanodots derived from hydrosoluble chitosan for mercury ion sensing via smartphone APP. Biosens. Bioelectron. 2016, 79, 1–8. [Google Scholar] [CrossRef] [PubMed]
- Sciortino, A.; Cannizzo, A.; Messina, F. Carbon Nanodots: A Review—From the Current Understanding of the Fundamental Photophysics to the Full Control of the Optical Response. C—J. Carbon Res. 2018, 4, 67. [Google Scholar] [CrossRef]
- Meng, X.; Zhang, C.; Dong, C.; Sun, W.; Ji, D.; Ding, Y. Carbon quantum dots assisted strategy to synthesize Co@NC for boosting photocatalytic hydrogen evolution performance of CdS. Chem. Eng. J. 2020, 389, 124432. [Google Scholar] [CrossRef]
- Papaioannou, N.; Marinovic, A.; Yoshizawa, N.; Goode, A.E.; Fay, M.; Khlobystov, A.; Titirici, M.M.; Sapelkin, A. Structure and solvents effects on the optical properties of sugar-derived carbon nanodots. Sci. Rep. 2018, 8, 6559. [Google Scholar] [CrossRef]
- Liu, Y.; Huang, H.; Cao, W.; Mao, B.; Liu, Y.; Kang, Z. Advances in carbon dots: From the perspective of traditional quantum dots. Mater. Chem. Front. 2020, 4, 1586–1613. [Google Scholar] [CrossRef]
- Hassan, M.; Haque, E.; Reddy, K.R.; Minett, A.I.; Chen, J.; Gomes, V.G. Edge-enriched graphene quantum dots for enhanced photo-luminescence and supercapacitance. Nanoscale 2014, 6, 11988–11994. [Google Scholar] [CrossRef]
- Tang, J.; Zhang, J.; Zhang, Y.; Xiao, Y.; Shi, Y.; Chen, Y.; Ding, L.; Xu, W. Influence of Group Modification at the Edges of Carbon Quantum Dots on Fluorescent Emission. Nanoscale Res. Lett. 2019, 14. [Google Scholar] [CrossRef] [PubMed]
- Pan, D.; Zhang, J.; Li, Z.; Wu, M. Hydrothermal route for cutting graphene sheets into blue-luminescent graphene quantum dots. Adv. Mater. 2010, 22, 734–738. [Google Scholar] [CrossRef] [PubMed]
- Song, L.; Shi, J.; Lu, J.; Lu, C. Structure observation of graphene quantum dots by single-layered formation in layered confinement space. Chem. Sci. 2015, 6, 4846–4850. [Google Scholar] [CrossRef] [PubMed]
- Jindal, S.; Giripunje, S.M. An insight into electronic and optical properties of multilayer graphene quantum dots synthesized by hydrothermal approach. Synth. Met. 2018, 239, 36–42. [Google Scholar] [CrossRef]
- Wimmenauer, C.; Scheller, J.; Fasbender, S.; Heinzel, T. Single-particle energy–and optical absorption–spectra of multilayer graphene quantum dots. Superlattices Microstruct. 2019, 132, 106171. [Google Scholar] [CrossRef]
- Huang, J.J.; Zhong, Z.F.; Rong, M.Z.; Zhou, X.; Chen, X.D.; Zhang, M.Q. An easy approach of preparing strongly luminescent carbon dots and their polymer based composites for enhancing solar cell efficiency. Carbon N. Y. 2014, 70, 190–198. [Google Scholar] [CrossRef]
- Keerthana, A.K.; Ashraf, P.M. Carbon nanodots synthesized from chitosan and its application as a corrosion inhibitor in boat-building carbon steel BIS2062. Appl. Nanosci. 2020, 10, 1061–1071. [Google Scholar] [CrossRef]
- Ren, X.; Liang, W.; Wang, P.; Bunker, C.E.; Coleman, M.; Teisl, L.R.; Cao, L.; Sun, Y.P. A new approach in functionalization of carbon nanoparticles for optoelectronically relevant carbon dots and beyond. Carbon N. Y. 2019, 141, 553–560. [Google Scholar] [CrossRef]
- Sun, Y.P.; Zhou, B.; Lin, Y.; Wang, W.; Fernando, K.A.S.; Pathak, P.; Meziani, M.J.; Harruff, B.A.; Wang, X.; Wang, H.; et al. Quantum-sized carbon dots for bright and colorful photoluminescence. J. Am. Chem. Soc. 2006, 128, 7756–7757. [Google Scholar] [CrossRef]
- Sekiya, R.; Uemura, Y.; Murakami, H.; Haino, T. White-Light-Emitting Edge-Functionalized Graphene Quantum Dots. Angew. Chem. 2014, 126, 5725–5729. [Google Scholar] [CrossRef]
- Cayuela, A.; Soriano, M.L.; Carrillo-Carrión, C.; Valcárcel, M. Semiconductor and carbon-based fluorescent nanodots: The need for consistency. Chem. Commun. 2016, 52, 1311–1326. [Google Scholar] [CrossRef] [PubMed]
- D’Amora, M.; Giordani, S. Carbon Nanomaterials for Nanomedicine. Smart Nanopart. Biomed. 2018, 2018, 103–113. [Google Scholar] [CrossRef]
- Abu Rabe, D.I.; Al Awak, M.M.; Yang, F.; Okonjo, P.A.; Dong, X.; Teisl, L.R.; Wang, P.; Tang, Y.; Pan, N.; Sun, Y.P.; et al. The dominant role of surface functionalization in carbon dots’ photo-activated antibacterial activity. Int. J. Nanomed. 2019, 14, 2655–2665. [Google Scholar] [CrossRef] [PubMed]
- Bi, R.; Zhang, Q.; Zhang, R.; Su, Y.; Jiang, Z. Thin film nanocomposite membranes incorporated with graphene quantum dots for high flux and antifouling property. J. Memb. Sci. 2018, 553, 17–24. [Google Scholar] [CrossRef]
- Khairkar, S.R.; Pansare, A.V.; Shedge, A.A.; Chhatre, S.Y.; Suresh, A.K.; Chakrabarti, S.; Patil, V.R.; Nagarkar, A.A. Hydrophobic interpenetrating polyamide-PDMS membranes for desalination, pesticides removal and enhanced chlorine tolerance. Chemosphere 2020, 258, 127179. [Google Scholar] [CrossRef] [PubMed]
- Atkinson, A.J.; Wang, J.; Grzebyk, K.; Zhang, Z.; Jung, D.; Zeng, D.; Pollard, A.; Gold, A.; Coronell, O. Scalable fabrication of anti-biofouling membranes through 2-aminoimidazole incorporation during polyamide casting. J. Memb. Sci. 2019, 579, 151–161. [Google Scholar] [CrossRef]
- Firouzjaei, M.D.; Seyedpour, S.F.; Aktij, S.A.; Giagnorio, M.; Bazrafshan, N.; Mollahosseini, A.; Samadi, F.; Ahmadalipour, S.; Firouzjaei, F.D.; Esfahani, M.R.; et al. Recent advances in functionalized polymer membranes for biofouling control and mitigation in forward osmosis. J. Memb. Sci. 2020, 596, 117604. [Google Scholar] [CrossRef]
- Zhang, M.; Zhang, K.; De Gusseme, B.; Verstraete, W. Biogenic silver nanoparticles (bio-Ag 0) decrease biofouling of bio-Ag 0/PES nanocomposite membranes. Water Res. 2012, 46, 2077–2087. [Google Scholar] [CrossRef]
- Chen, H.; Wu, J.; Wu, M.; Jia, H. Preparation and antibacterial activities of copper nanoparticles encapsulated by carbon. New Carbon Mater. 2019, 34, 382–389. [Google Scholar] [CrossRef]
- Pasmore, M.; Todd, P.; Smith, S.; Baker, D.; Silverstein, J.A.; Coons, D.; Bowman, C.N. Effects of ultrafiltration membrane surface properties on Pseudomonas aeruginosa biofilm initiation for the purpose of reducing biofouling. J. Memb. Sci. 2001, 194, 15–32. [Google Scholar] [CrossRef]
- Leong, J.X.; Daud, W.R.W.; Ghasemi, M.; Liew, K.B.; Ismail, M. Ion exchange membranes as separators in microbial fuel cells for bioenergy conversion: A comprehensive review. Renew. Sustain. Energy Rev. 2013, 28, 575–587. [Google Scholar] [CrossRef]
- Al-Gharabli, S.; Al-Omari, B.; Kujawski, W.; Kujawa, J. Biomimetic hybrid membranes with covalently anchored chitosan–Material design, transport and separation. Desalination 2020, 491, 114550. [Google Scholar] [CrossRef]
- Fu, J.; Ji, J.; Yuan, W.; Shen, J. Construction of anti-adhesive and antibacterial multilayer films via layer-by-layer assembly of heparin and chitosan. Biomaterials 2005, 26, 6684–6692. [Google Scholar] [CrossRef] [PubMed]
- Zheng, B.; Wang, J.; Wang, F.B.; Xia, X.H. Synthesis of nitrogen doped graphene with high electrocatalytic activity toward oxygen reduction reaction. Electrochem. Commun. 2013, 28, 24–26. [Google Scholar] [CrossRef]
- Benn, M.H.; Jones, A.S. 761. Glycosylureas. Part I. Preparation and some reactions of D-glucosylureas and D-ribosylureas. J. Chem. Soc. 1960, 3837–3841. [Google Scholar] [CrossRef]
- McKay, M.J.; Nguyen, H.M. Recent developments in glycosyl urea synthesis. Carbohydr. Res. 2014, 385, 18–44. [Google Scholar] [CrossRef]
- Jridi, M.; Hajji, S.; Ayed, H.B.; Lassoued, I.; Mbarek, A.; Kammoun, M.; Souissi, N.; Nasri, M. Physical, structural, antioxidant and antimicrobial properties of gelatin-chitosan composite edible films. Int. J. Biol. Macromol. 2014, 67, 373–379. [Google Scholar] [CrossRef]
- Kundu, S.; Xia, W.; Busser, W.; Becker, M.; Schmidt, D.A.; Havenith, M.; Muhler, M. The formation of nitrogen-containing functional groups on carbon nanotube surfaces: A quantitative XPS and TPD study. Phys. Chem. Chem. Phys. 2010, 12, 4351–4359. [Google Scholar] [CrossRef]
- Wang, W.; Zeng, Z.; Zeng, G.; Zhang, C.; Xiao, R.; Zhou, C.; Xiong, W.; Yang, Y.; Lei, L.; Liu, Y.; et al. Sulfur doped carbon quantum dots loaded hollow tubular g-C3N4 as novel photocatalyst for destruction of Escherichia coli and tetracycline degradation under visible light. Chem. Eng. J. 2019, 378, 122132. [Google Scholar] [CrossRef]
- Shang, J.; Ma, L.; Li, J.; Ai, W.; Yu, T.; Gurzadyan, G.G. The origin of fluorescence from graphene oxide. Sci. Rep. 2012, 2, 792. [Google Scholar] [CrossRef]
- Tetsuka, H.; Asahi, R.; Nagoya, A.; Okamoto, K.; Tajima, I.; Ohta, R.; Okamoto, A. Optically tunable amino-functionalized graphene quantum dots. Adv. Mater. 2012, 24, 5333–5338. [Google Scholar] [CrossRef] [PubMed]
- Sandeep Kumar, G.; Roy, R.; Sen, D.; Ghorai, U.K.; Thapa, R.; Mazumder, N.; Saha, S.; Chattopadhyay, K.K. Amino-functionalized graphene quantum dots: Origin of tunable heterogeneous photoluminescence. Nanoscale 2014, 6, 3384–3391. [Google Scholar] [CrossRef] [PubMed]
- Cushing, S.K.; Li, M.; Huang, F.; Wu, N. Origin of strong excitation wavelength dependent fluorescence of graphene oxide. ACS Nano 2014, 8, 1002–1013. [Google Scholar] [CrossRef] [PubMed]
- Hua, X.W.; Bao, Y.W.; Wang, H.Y.; Chen, Z.; Wu, F.G. Bacteria-derived fluorescent carbon dots for microbial live/dead differentiation. Nanoscale 2017, 9, 2150–2161. [Google Scholar] [CrossRef] [PubMed]
- Jiang, Y.W.; Gao, G.; Zhang, X.; Jia, H.R.; Wu, F.G. Antimicrobial carbon nanospheres. Nanoscale 2017, 9, 15786–15795. [Google Scholar] [CrossRef] [PubMed]
- Liu, J.; Lu, S.; Tang, Q.; Zhang, K.; Yu, W.; Sun, H.; Yang, B. One-step hydrothermal synthesis of photoluminescent carbon nanodots with selective antibacterial activity against Porphyromonas gingivalis. Nanoscale 2017, 9, 7135–7142. [Google Scholar] [CrossRef]
- Dizaj, S.M.; Lotfipour, F.; Barzegar-Jalali, M.; Zarrintan, M.H.; Adibkia, K. Antimicrobial activity of the metals and metal oxide nanoparticles. Mater. Sci. Eng. C 2014, 44, 278–284. [Google Scholar] [CrossRef]

| Sample | C (%) | O (%) | N (%) |
|---|---|---|---|
| CS180 | 72.5 | 20.0 | 7.5 |
| CSU180 | 73.1 | 16.6 | 10.3 |
| Sample | Pyridinic | Amine/Amide | Quaternary |
|---|---|---|---|
| CS180 | 100 (100) * | 113 (156) | 102 (103) |
| CSU180 | 141 (228) | 175 (355) | 115 (88) |
| Sample | Surface Charge (mV) |
|---|---|
| CS180 | −14.3 ± 1.4 |
| CSU180 | 15.6 ± 2.8 |
| Sample | Contact Angle ± SD [°] |
|---|---|
| unmodified | 60.8 ± 1.0 |
| M-CS180 | 70.3 ± 1.2 |
| M-CSU180 | 24.0 ± 0.9 |
| E. coli | P. aeruginosa | K. oxytoca | |
|---|---|---|---|
| Unmodified | +++++ | +++++ | +++++ |
| CS180 | +++++ | + | + |
| CSU180 | +++++ | ++ | ++++ |
Publisher’s Note: MDPI stays neutral with regard to jurisdictional claims in published maps and institutional affiliations. |
© 2020 by the authors. Licensee MDPI, Basel, Switzerland. This article is an open access article distributed under the terms and conditions of the Creative Commons Attribution (CC BY) license (http://creativecommons.org/licenses/by/4.0/).
Share and Cite
Rybarczyk, M.K.; Gontarek-Castro, E.; Ollik, K.; Lieder, M. Biomass-Derived Nitrogen Functionalized Carbon Nanodots and Their Anti-Biofouling Properties. Processes 2021, 9, 61. https://doi.org/10.3390/pr9010061
Rybarczyk MK, Gontarek-Castro E, Ollik K, Lieder M. Biomass-Derived Nitrogen Functionalized Carbon Nanodots and Their Anti-Biofouling Properties. Processes. 2021; 9(1):61. https://doi.org/10.3390/pr9010061
Chicago/Turabian StyleRybarczyk, Maria K., Emilia Gontarek-Castro, Karolina Ollik, and Marek Lieder. 2021. "Biomass-Derived Nitrogen Functionalized Carbon Nanodots and Their Anti-Biofouling Properties" Processes 9, no. 1: 61. https://doi.org/10.3390/pr9010061
APA StyleRybarczyk, M. K., Gontarek-Castro, E., Ollik, K., & Lieder, M. (2021). Biomass-Derived Nitrogen Functionalized Carbon Nanodots and Their Anti-Biofouling Properties. Processes, 9(1), 61. https://doi.org/10.3390/pr9010061

